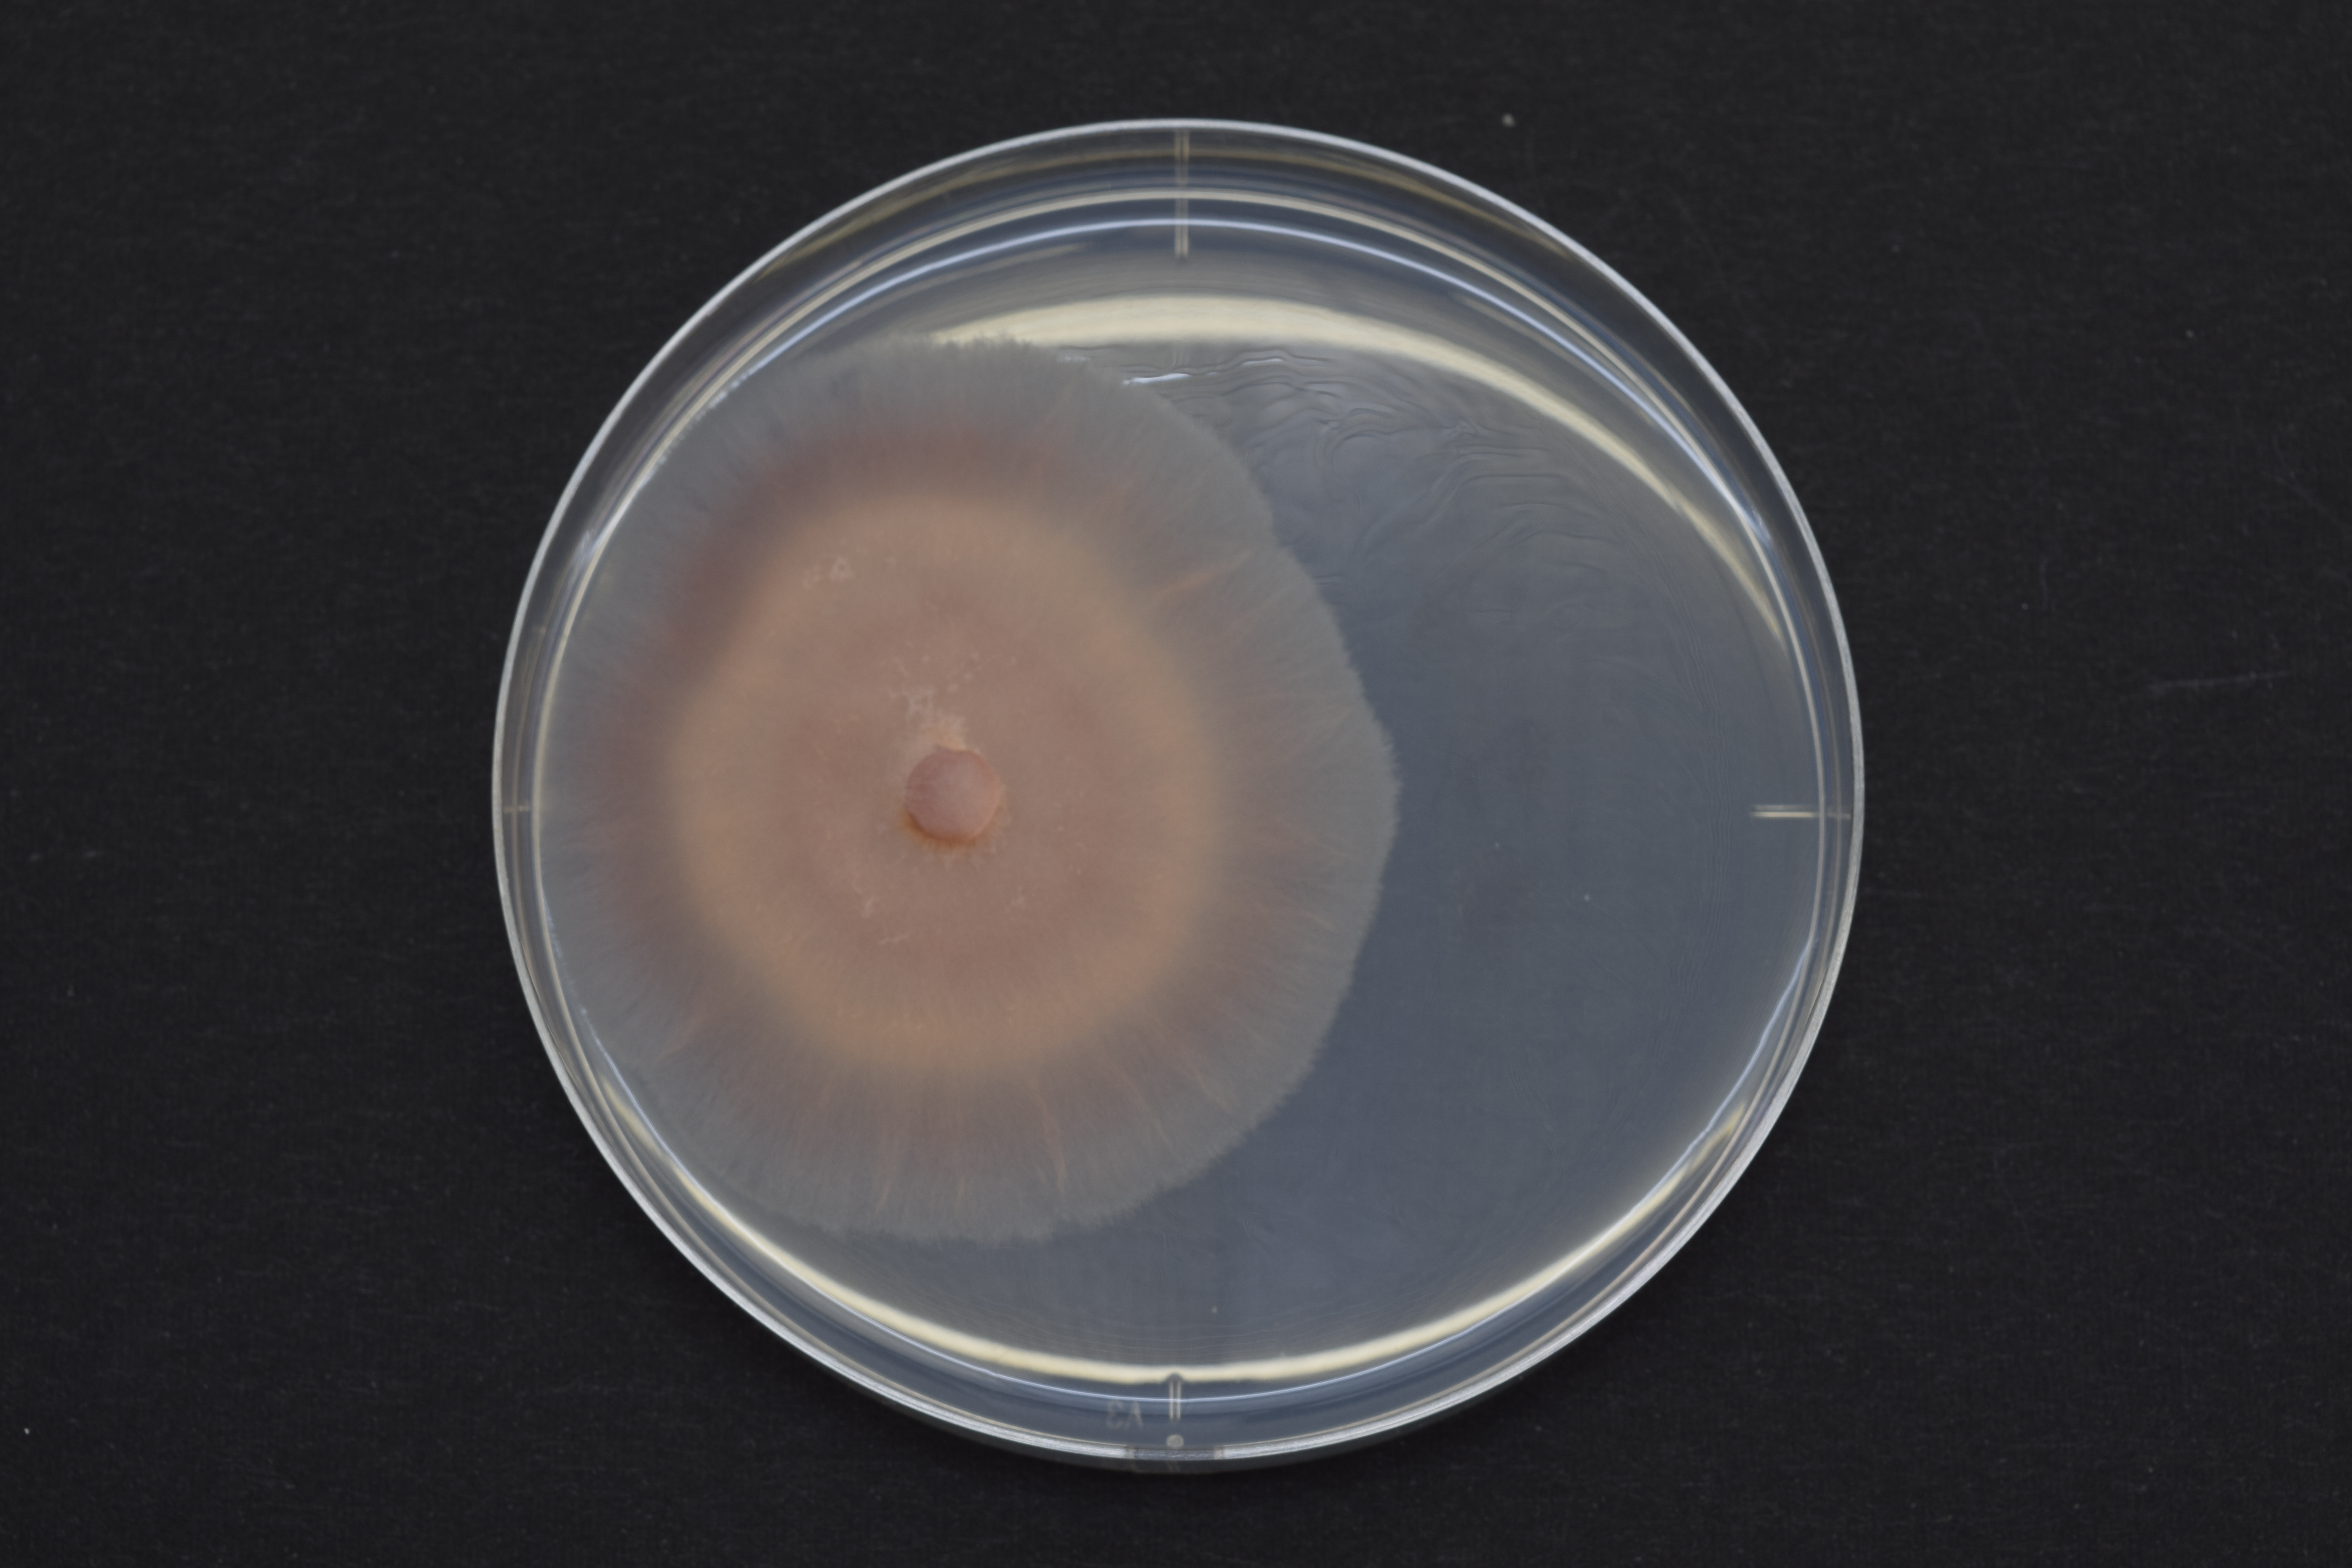
Fusarium oxysporum
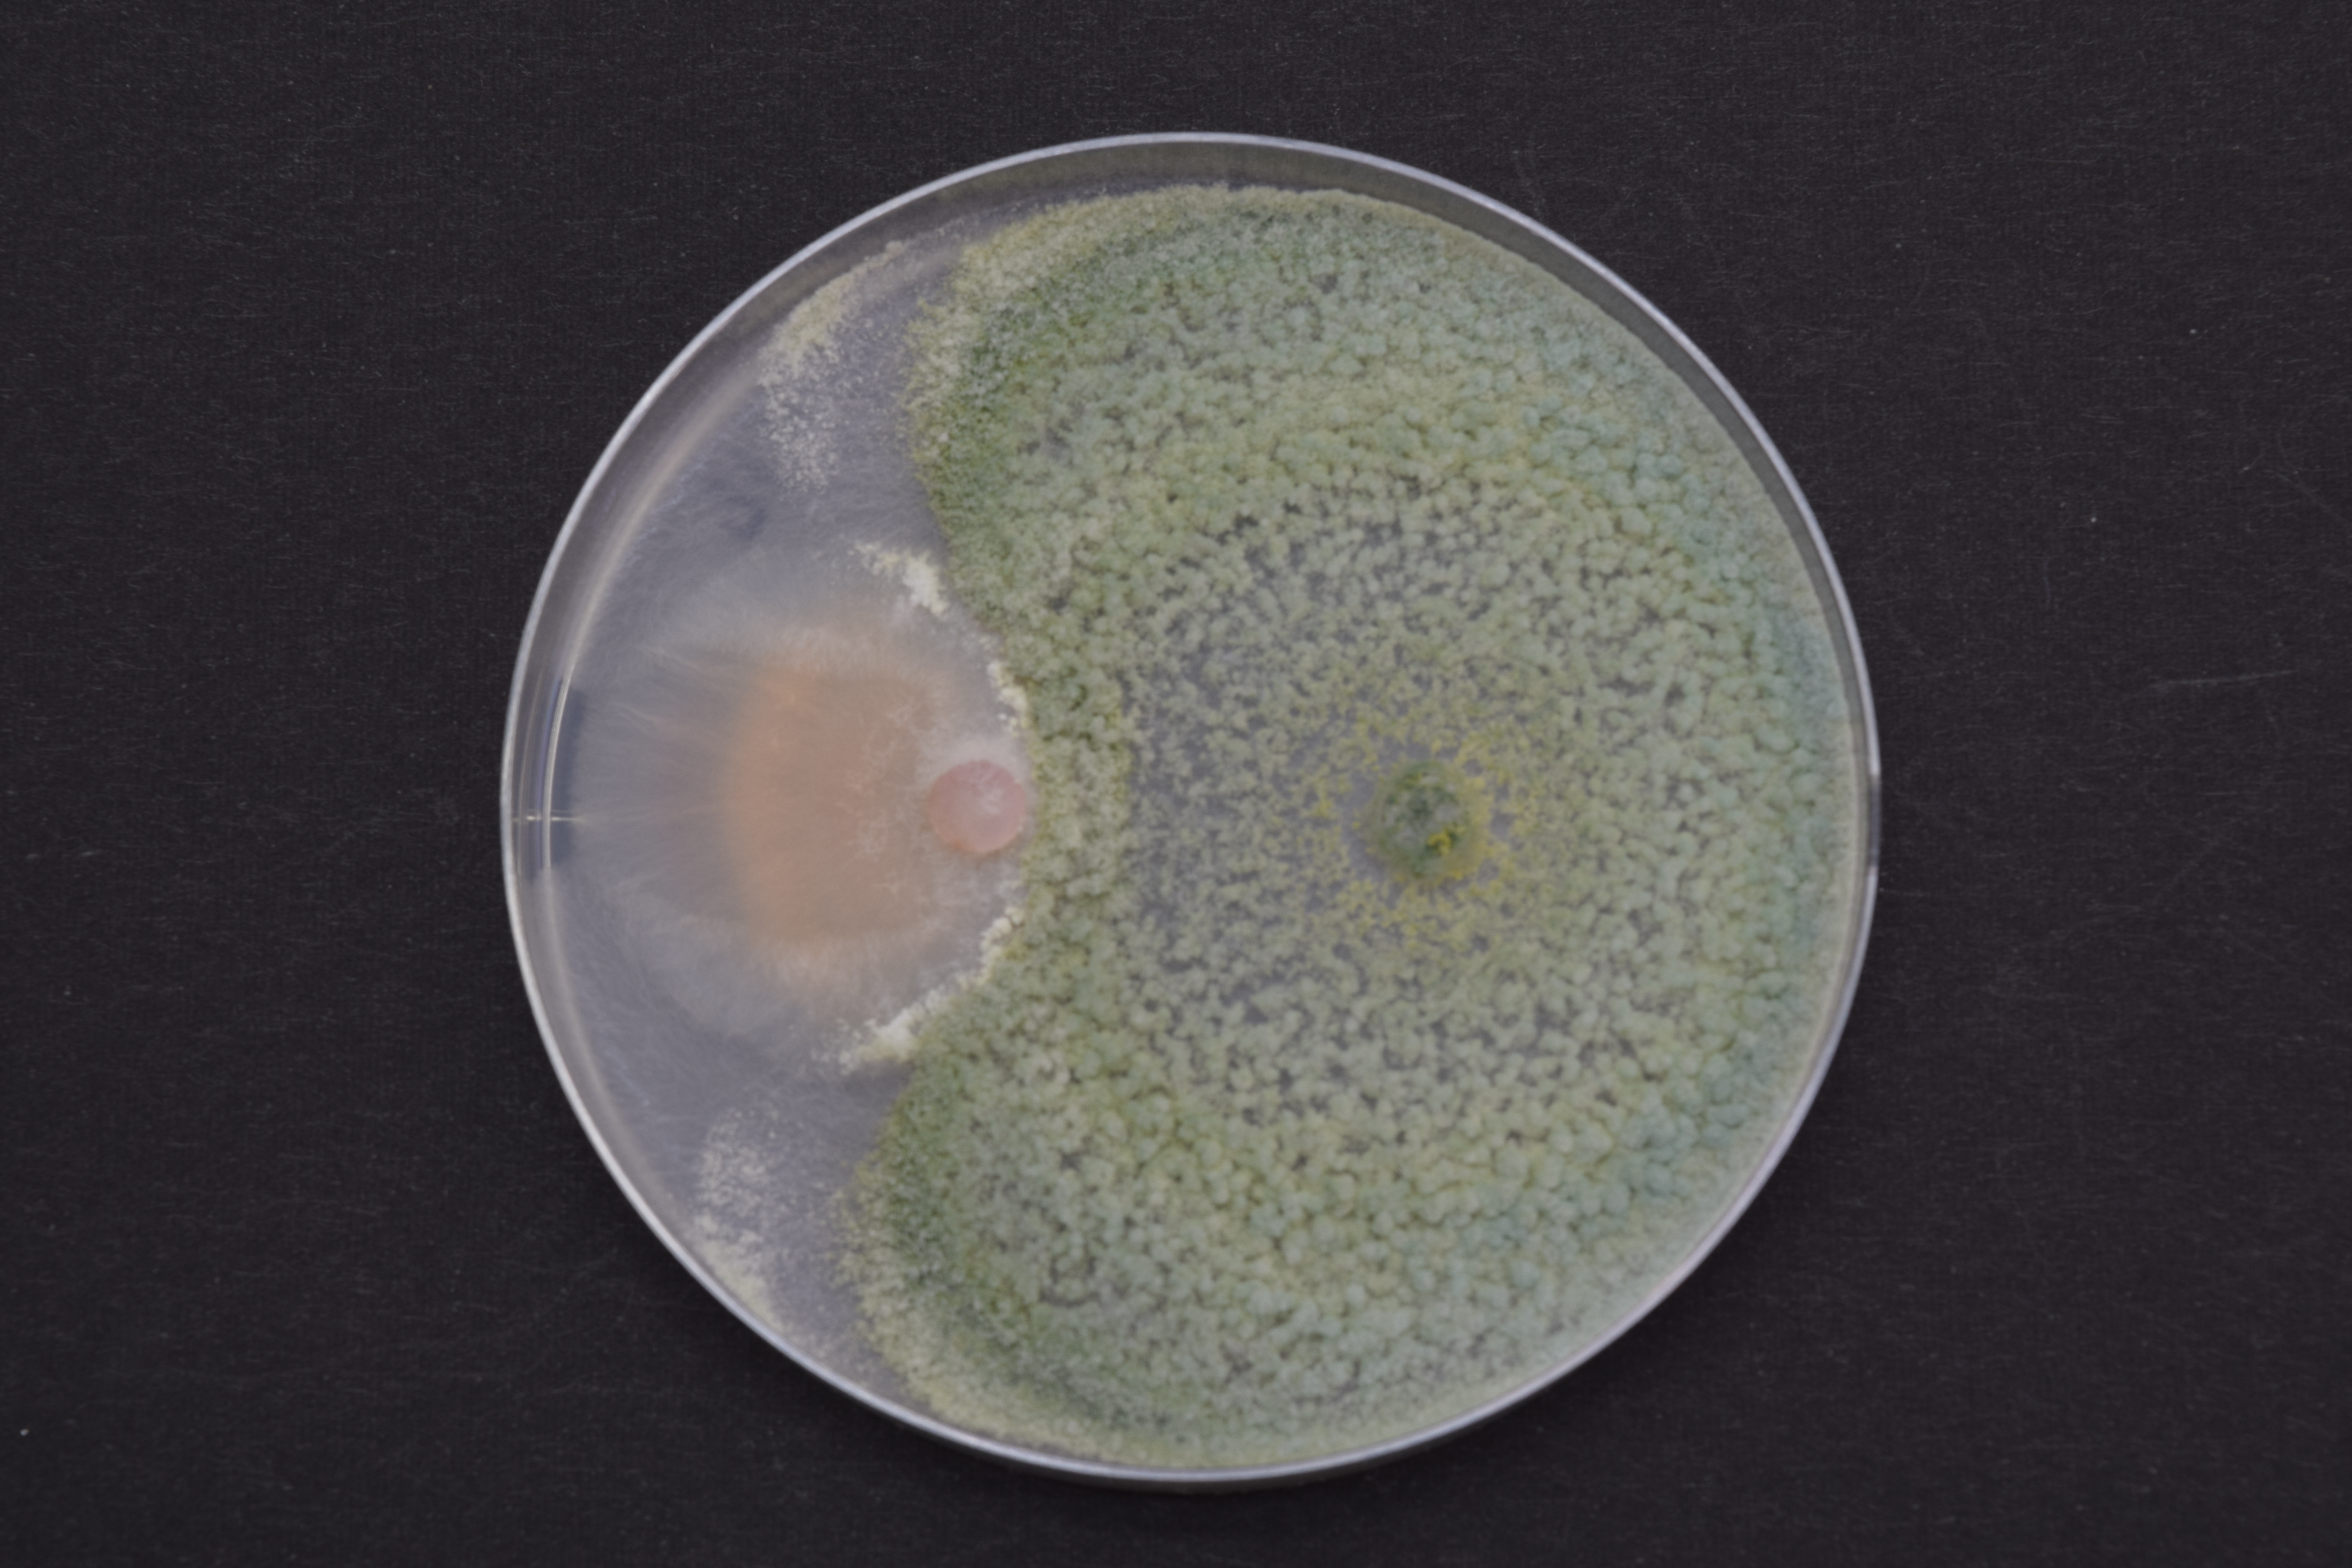
Fusarium oxysporum vs トリコデルマ
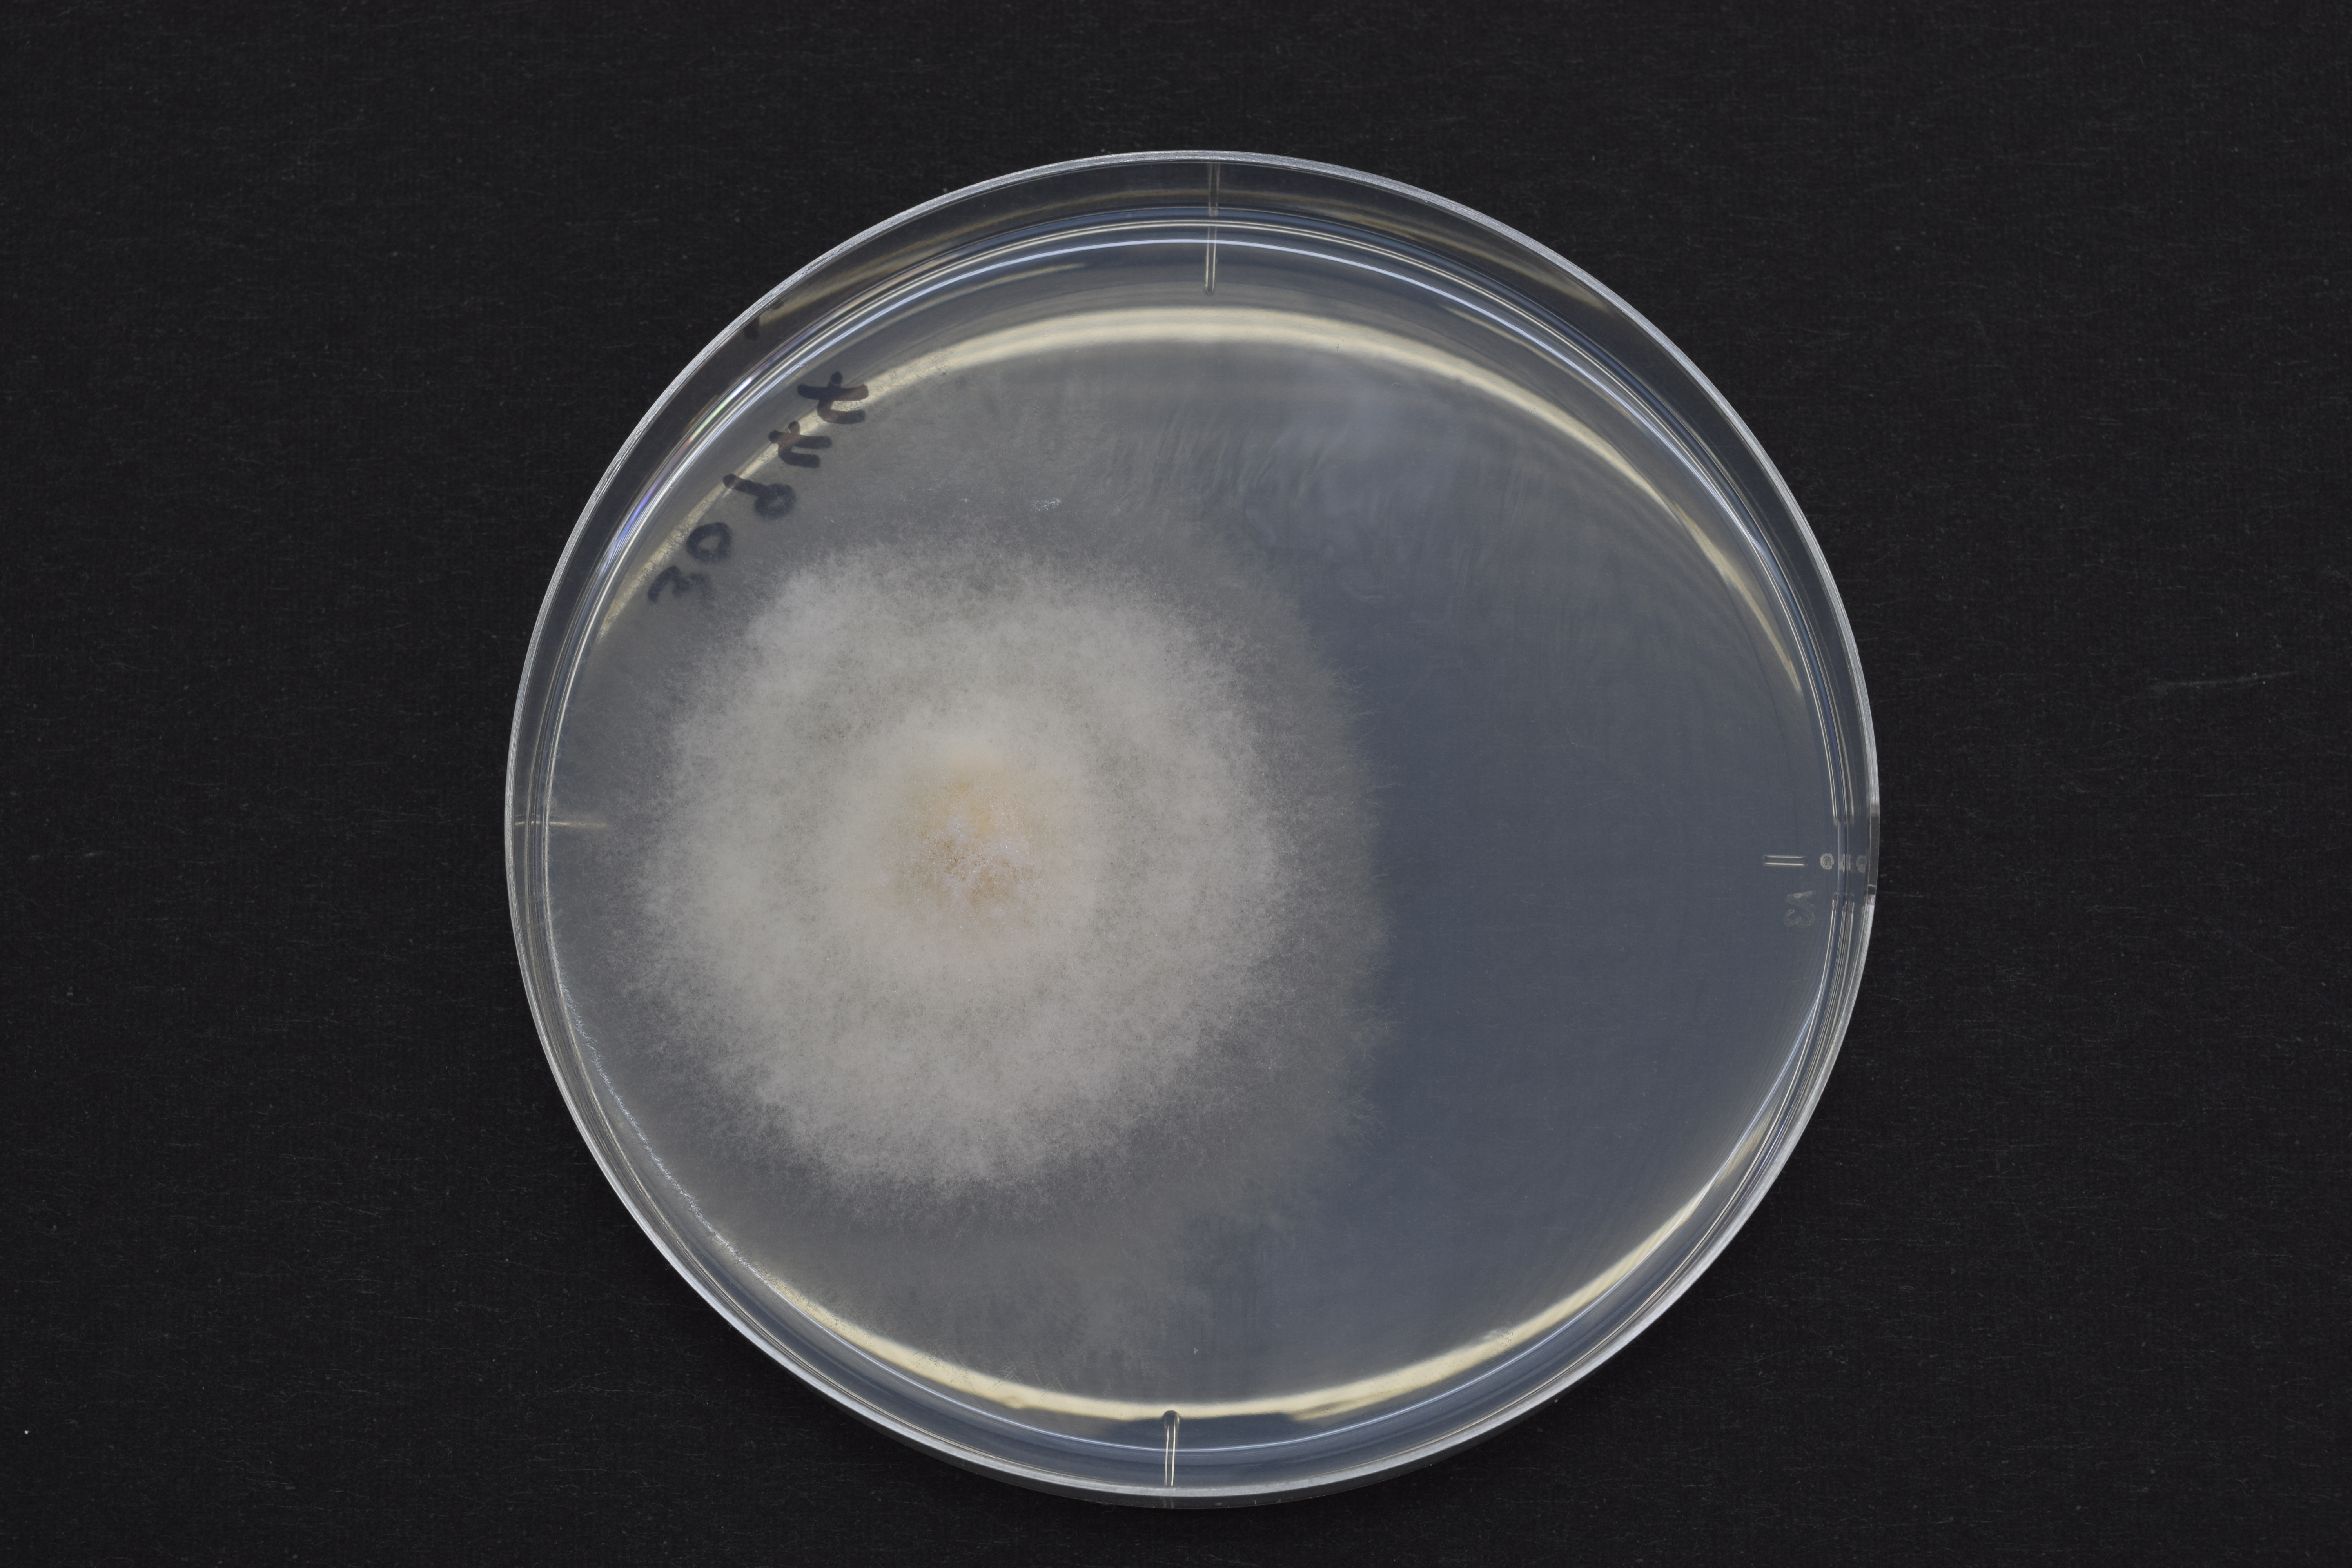
Rhizoctonia solani
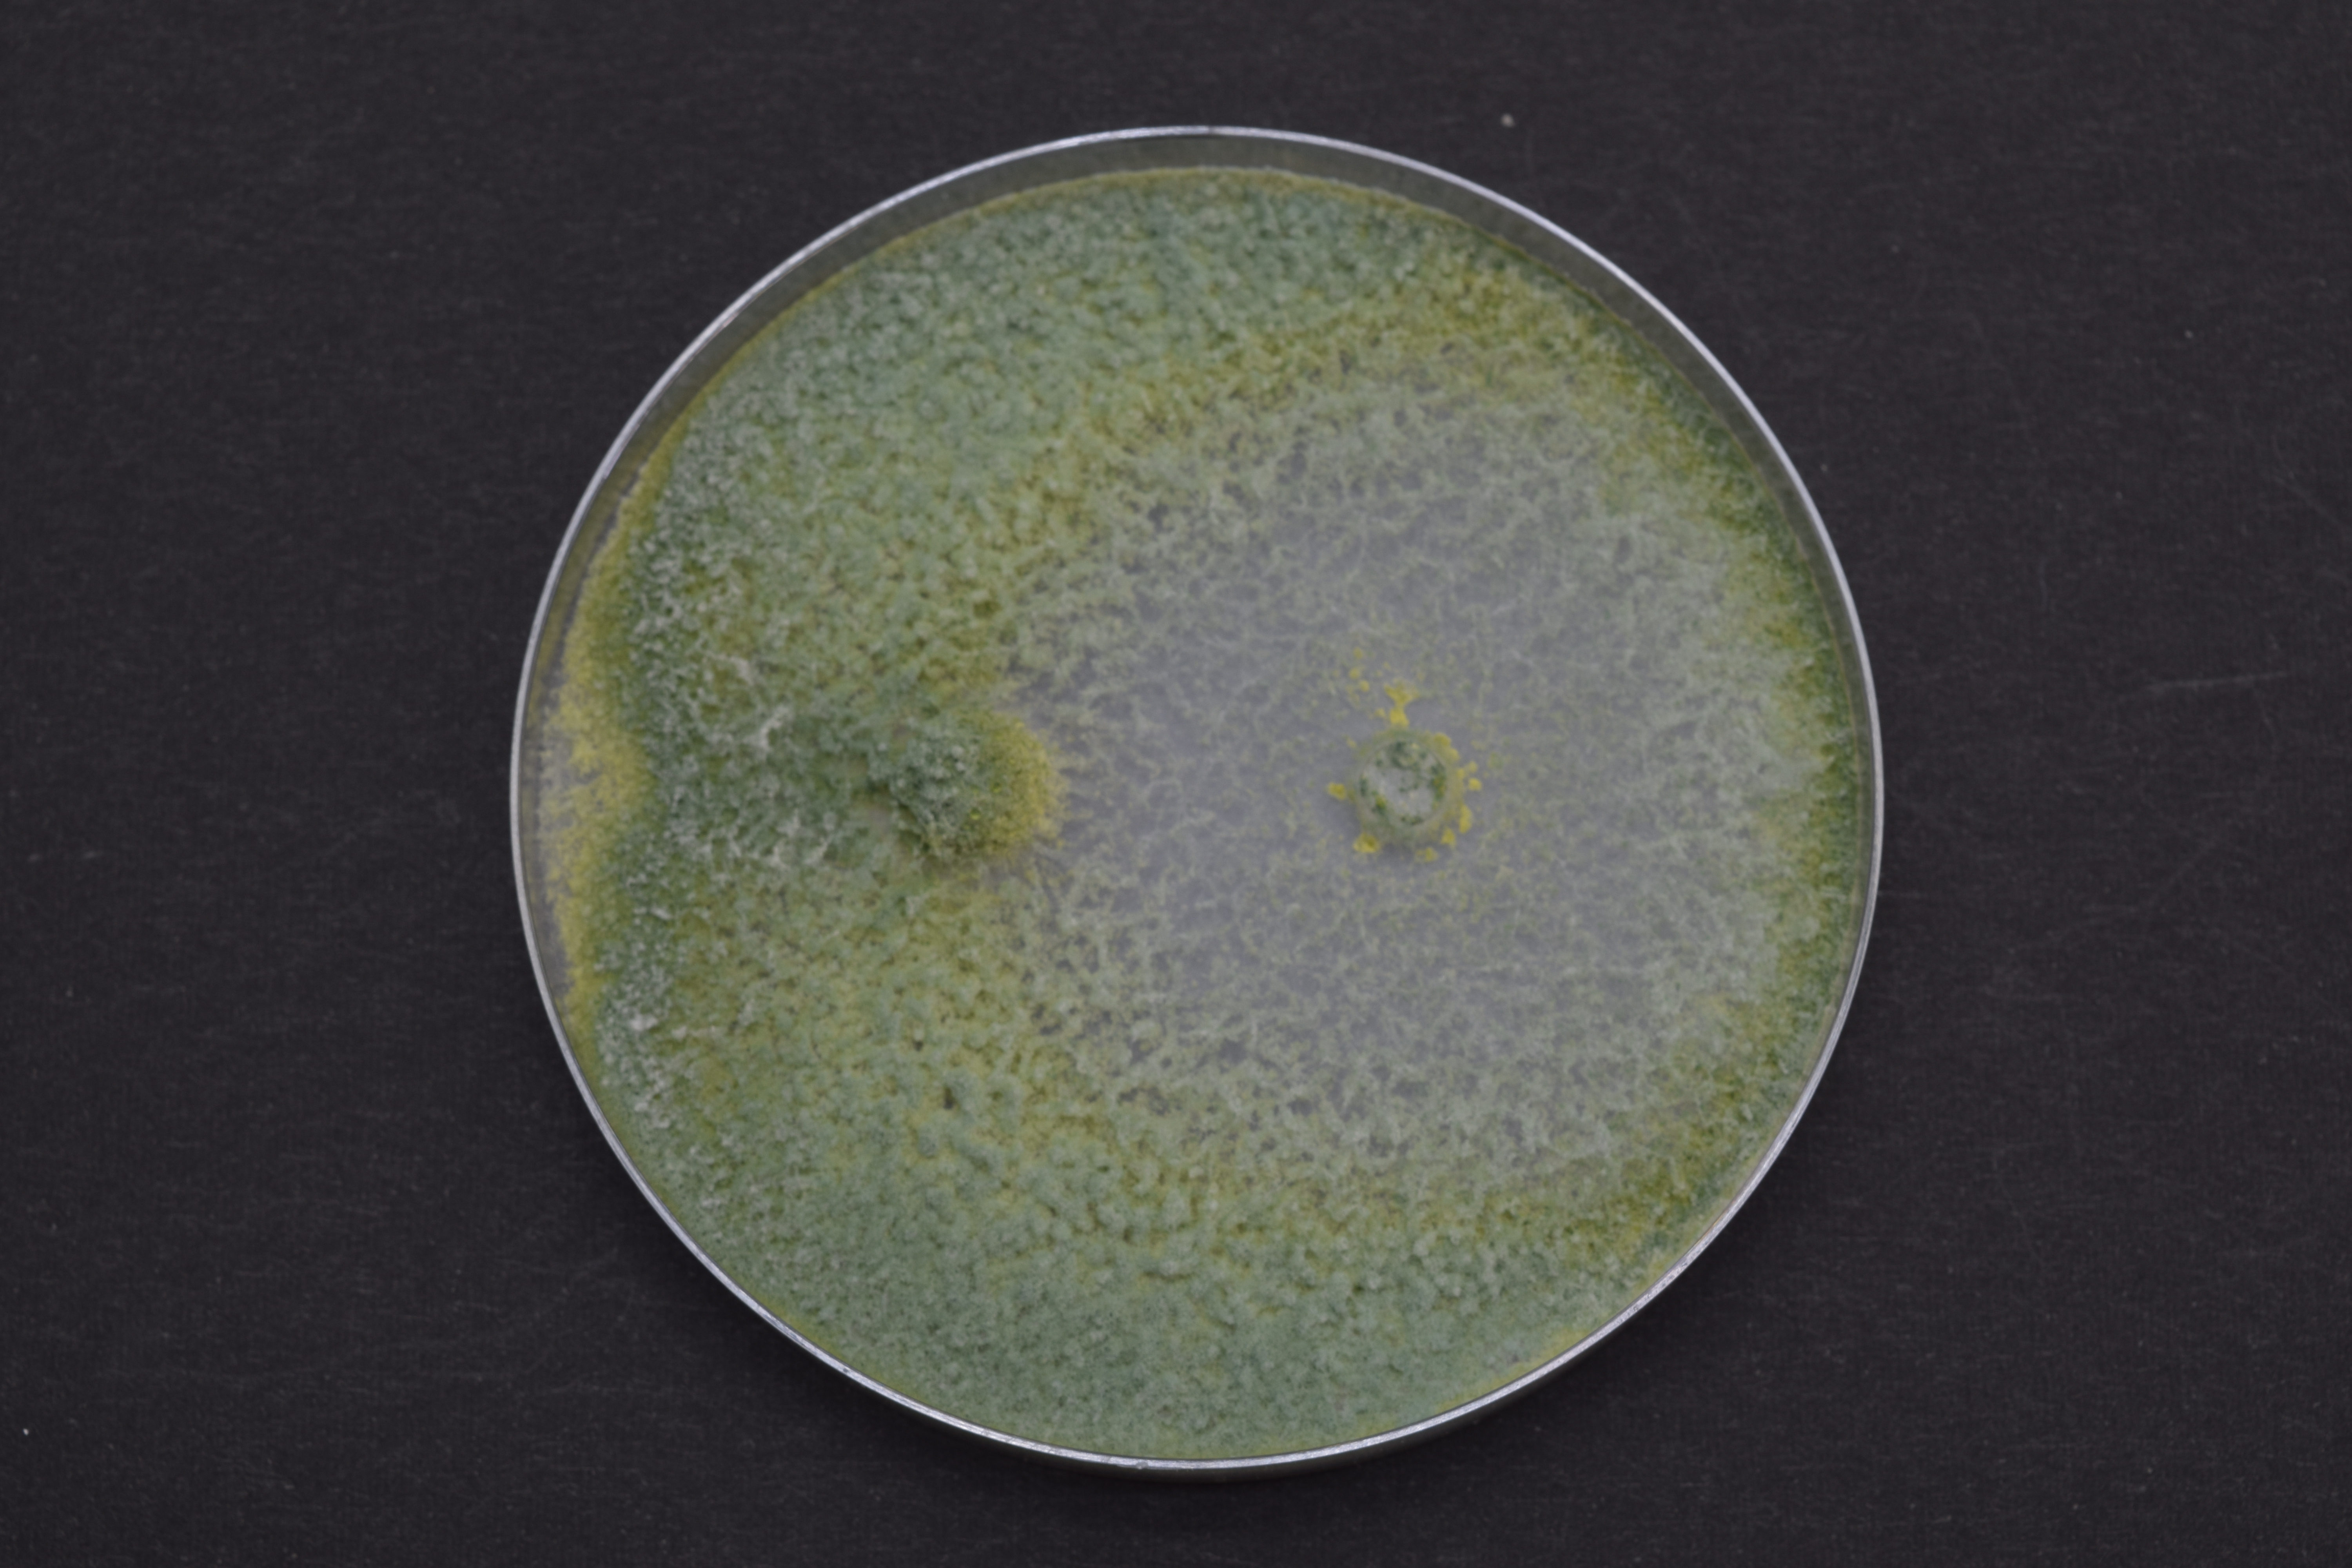
Rhizoctonia solani vs トリコデルマ

■ 微生物販売
取り扱い微生物の購入やお問い合わせはこちらから。
■ 土壌改良用素材
トリコデルマ属
トリコデルマは、溶菌作用などにより病原菌の増殖を抑える制菌作用を持つ微生物です。土壌や植物表面に存在し、病原菌の成長を阻害することで、農作物の健康を保ち、収穫量を向上させるのに役立ちます。
また、トリコデルマ属は、植物の根に寄生し根の成長を促進する効果が知られています。

フサリウム(左写真)を生育させたプレートにトリコデルマを植菌すると、フサリウムが浸食されます(右写真)。

リゾクトニア(左写真)を生育させたプレートにトリコデルマを植菌すると、リゾクトニアが浸食されます(右写真)。
■ 乳酸菌
ラクトバチルス プランタラム AB077
植物発酵液から単離した乳酸菌です。生育が早く、培養初期の制菌やpHを下げたいときに有効です。